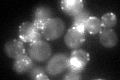
YMR109W
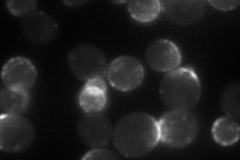
YMR109W
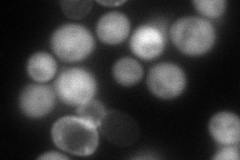
YMR109W
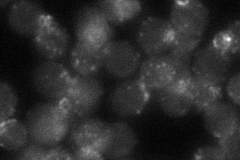
YMR109W
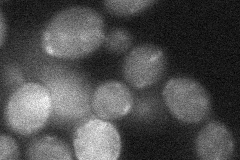
YMR109W
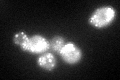
YMR109W

View description
One of two type I myosins; contains proline-rich tail homology 2 (TH2) and SH3 domains; MYO5 deletion has little effect on growth, but myo3 myo5 double deletion causes severe defects in growth and actin cytoskeleton organization
Localization:
Intensity:
Fold change:
Significance:
-
C’ GFP library in SD
punctate62.71 -
N' NOP1pr-GFP in SD
cell periphery,punctate,bud neck75.9186 -
N' TEF2pr-mCherry in SD
cell periphery,punctate,bud106.698 -
N' NATIVEpr-GFP in SD
punctate,bud neck36.6691 -
N' TEF2pr-VC and Cyto-VN in SD
below threshold27.4497 -
C’ GFP library in SD+DTT
punctate74.641.19No -
C’ GFP library in SD+H2O2

punctate73.091.16No -
C’ GFP library in Starvation Media

punctate71.641.14No -
C’ GFP library on the background of Pup2-DaMP

punctate -
C’ GFP library on the background of CCT mutant

punctate76.09461.2133No
